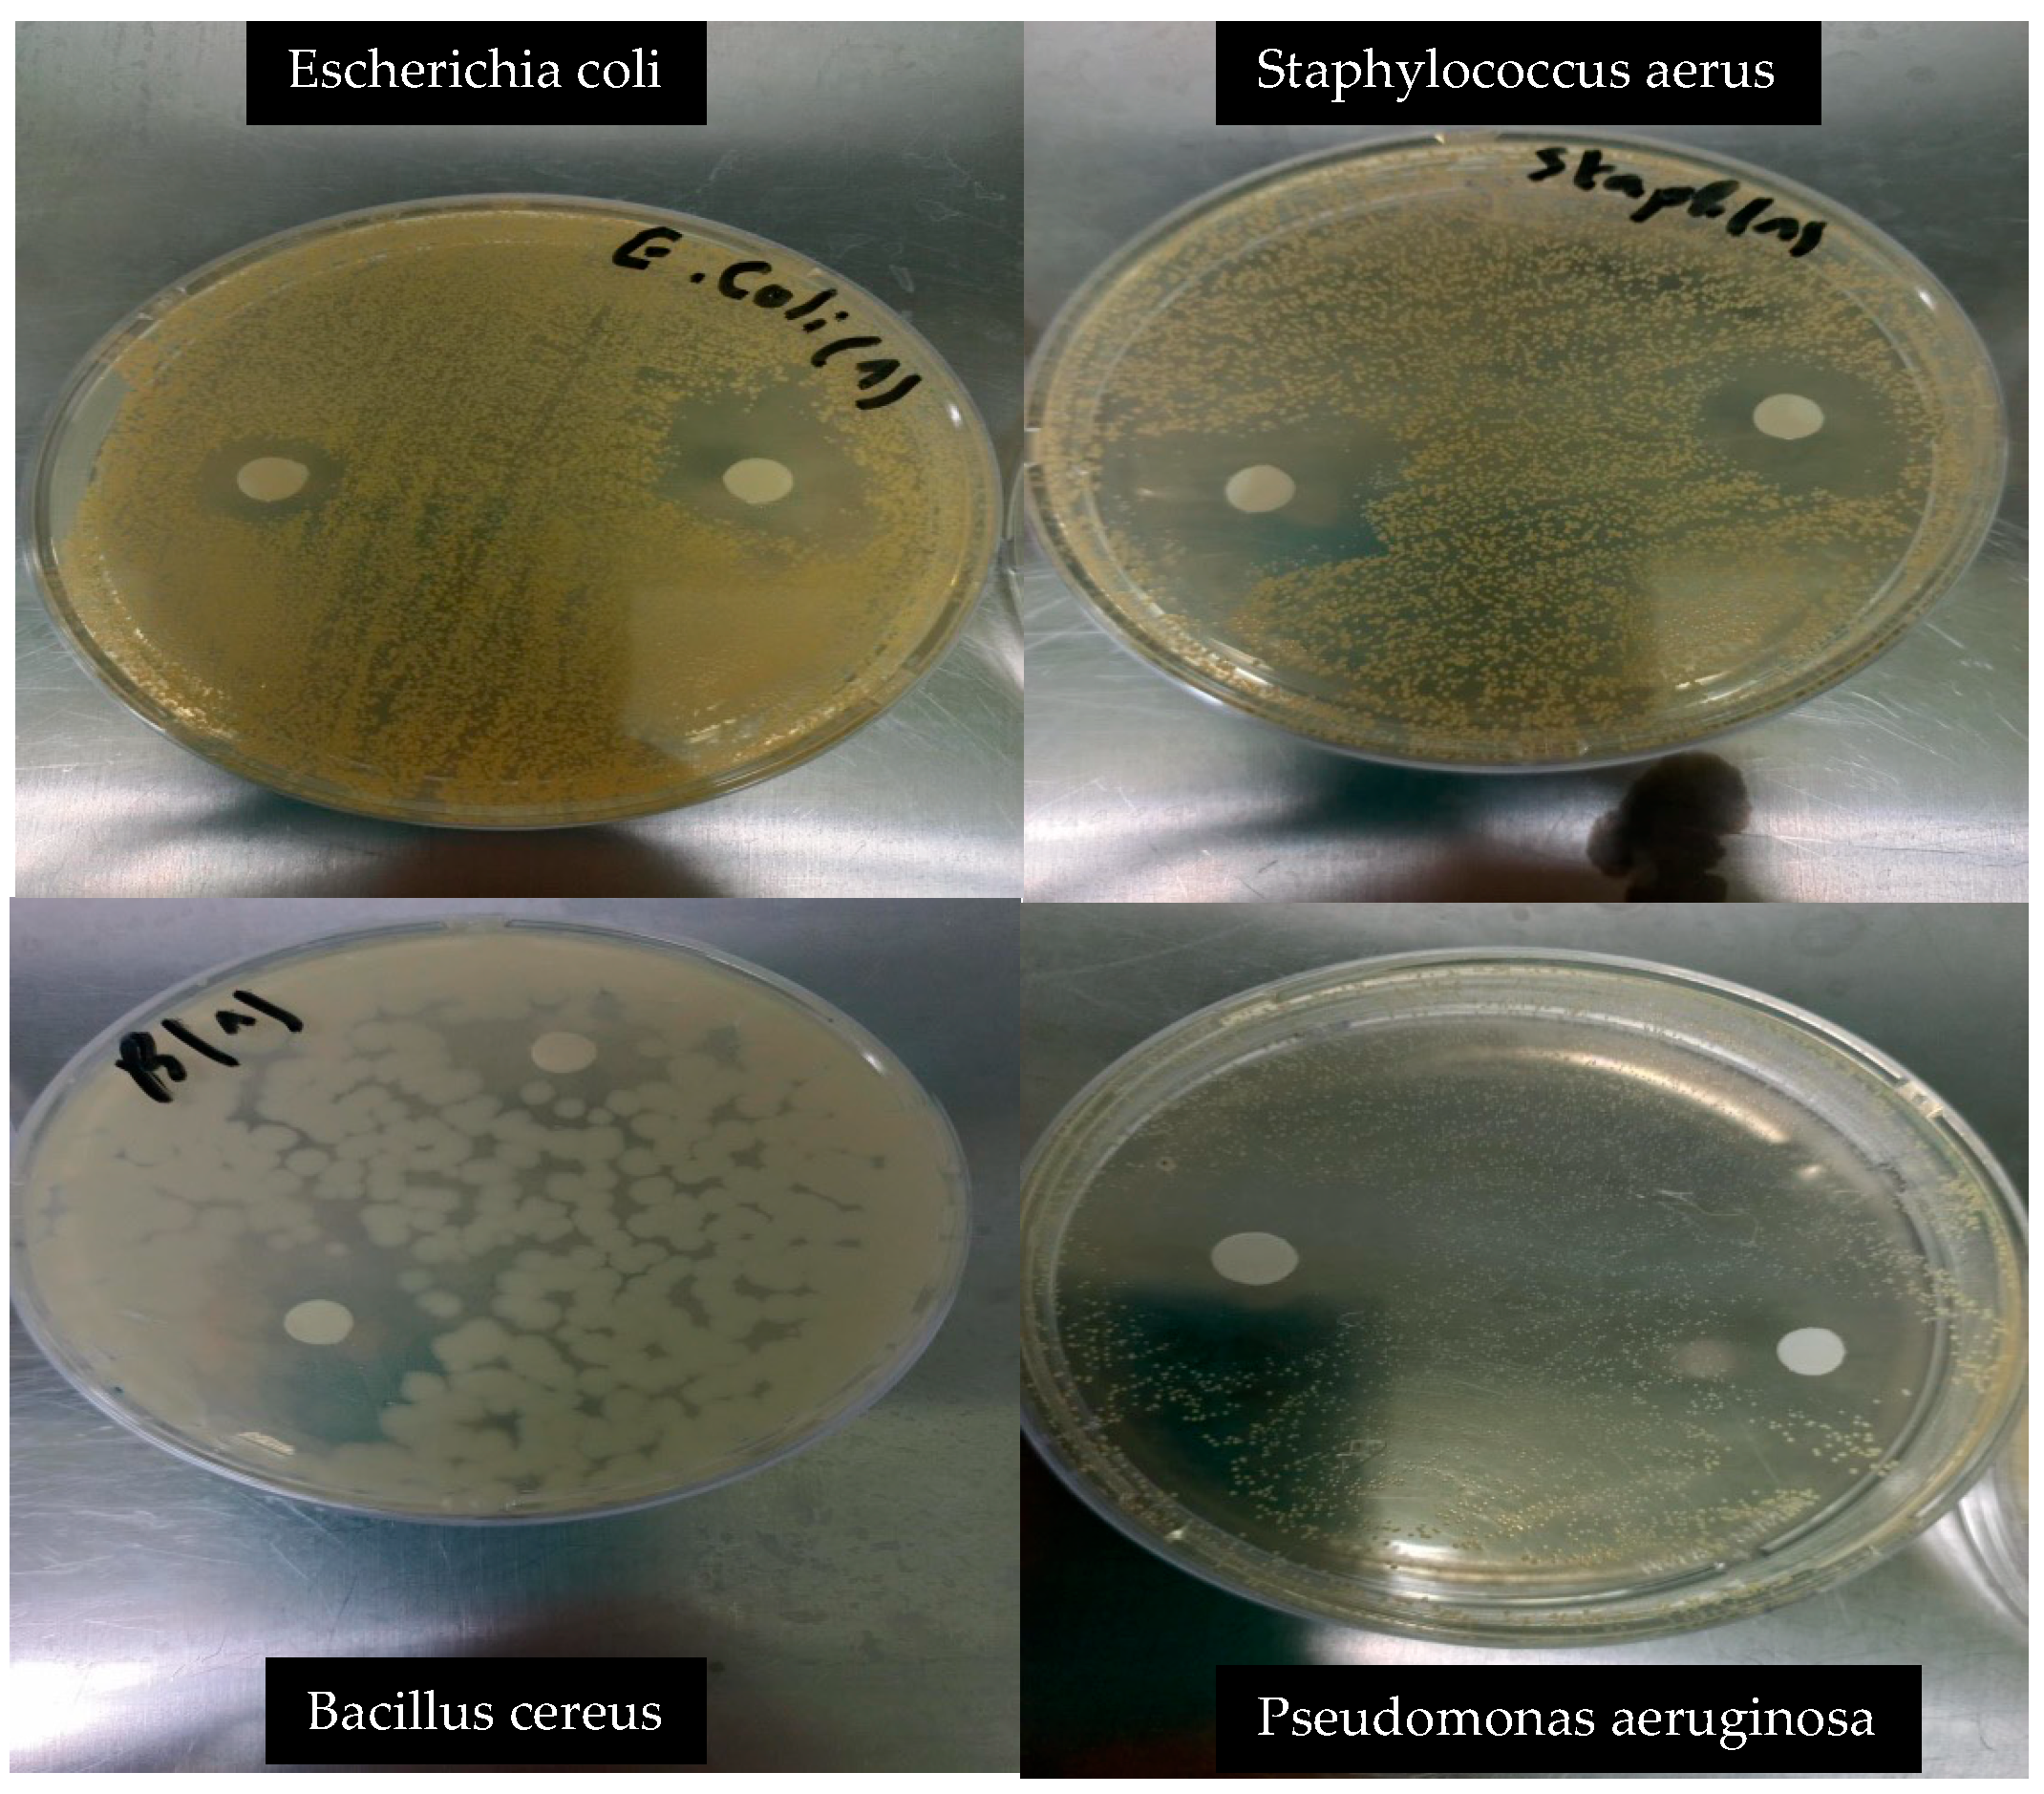
Foods 14 01968 g002

Ultrasound-Enhanced Ionotropic Gelation of Pectin for Lemon Essential Oil Encapsulation: Morphological Characterization and Application in Fresh-Cut Apple Preservation
Abstract
1. Introduction
2. Materials and Methods
2.1. Plant Material
2.2. Essential Oil Extraction via Hydrodistillation
2.3. Gas Chromatography–Mass Spectrometry (GC-MS) Analysis
2.4. Antibacterial Activity Assay
2.5. Antifungal Activity Assay
2.6. DPPH Radical Scavenging Assay
2.7. ABTS Radical Scavenging Assay
2.8. Ferric Reducing Antioxidant Power (FRAP) Assay
2.9. Phenanthroline Assay
2.10. Silver Nanoparticle (SNP) Assay
2.11. Encapsulation Process via Ionotropic Gelation
2.12. Scanning Electron Microscopy (SEM)
2.13. Preparation of Apple Slices and Treatments
- Control (C1): untreated;
- Blank capsules (C2): immersed for 1 min in a 2% (w/v) suspension of empty pectin capsules;
- LEO capsules (C3): immersed for 1 min in a 2% (w/v) suspension of EO-loaded capsules.
2.14. Color and Visual Browning Assessment
2.15. Microbial Load Evaluation
- Plate Count Agar (PCA) for total mesophilic aerobic bacteria (37 °C, 48 h);
- Potato Dextrose Agar (PDA) with 1% tartaric acid for yeasts and molds (25 °C, 72 h).
2.16. Weight Loss and Firmness
2.17. Statistical Analysis
3. Results
3.1. Chemical Composition of Lemon Essential Oil
3.2. Antibacterial Activity
3.3. Antifungal Activity
3.4. Antioxidant Activity
3.5. Encapsulation Efficiency
3.6. Evaluation of EO-Loaded Pectin Microcapsules in a Food Model
4. Conclusions
Author Contributions
Funding
Institutional Review Board Statement
Informed Consent Statement
Data Availability Statement
Acknowledgments
Conflicts of Interest
References
- Koch, P.; Dhua, S.; Mishra, P. Critical review on Citrus essential oil extracted from processing waste-based nanoemulsion: Preparation, characterization, and emerging food application. J. Essent. Oil Res. 2024, 36, 407–425. [Google Scholar] [CrossRef]
- Fernandes, B.; Oliveira, M.C.; Marques, A.C.; Dos Santos, R.G.; Serrano, C. Microencapsulation of Essential Oils and Oleoresins: Applications in Food Products. Foods 2024, 13, 3873. [Google Scholar] [CrossRef] [PubMed]
- Said, N.S.; Olawuyi, I.F.; Lee, W.Y. Pectin hydrogels: Gel-forming behaviors, mechanisms, and food applications. Gels 2023, 9, 732. [Google Scholar] [CrossRef]
- Freitas, C.M.P.; Coimbra, J.S.R.; Souza, V.G.L.; Sousa, R.C.S. Structure and applications of pectin in food, biomedical, and pharmaceutical industry: A review. Coatings 2021, 11, 922. [Google Scholar] [CrossRef]
- Qayum, A.; Rashid, A.; Liang, Q.; Wu, Y.; Cheng, Y.; Kang, L.; Liu, Y.; Zhou, C.; Hussain, M.; Ashokkumar, M.; et al. Ultrasonic and homogenization: An overview of the preparation of an edible protein–polysaccharide complex emulsion. Compr. Rev. Food Sci. Food Saf. 2023, 22, 4242–4281. [Google Scholar] [CrossRef] [PubMed]
- Kaur, G.; Khan, Z.S.; Toker, Ö.S.; Bhat, M.S.; Basyigit, B.; Kurt, A.; Rustagi, S.; Suri, S.; Hatami, S.; Fayaz, S.; et al. Innovative approaches to pectin processing: Enhancing techno-functional properties for applications in food and beyond. Bioact. Carbohydr. Diet. Fibre 2024, 32, 100437. [Google Scholar] [CrossRef]
- Das, P.; Panda, J.R.; Patro, C.N.; Sahu, B.; Patnaik, S.S. A comprehensive review of Nanoemulsion applications and their recent advancements. Curr. Nanomater. 2023, 8, 209–223. [Google Scholar] [CrossRef]
- Feng, L.; Wang, Y.; Liu, T.; Zhao, C.; Chen, Y.; Wang, F.; Bao, Y.; Zheng, J. Pectin-based emulsion gels prepared by acidic and ionotropic methods for intestinal targeted delivery in vitro. Food Hydrocoll. 2024, 154, 110118. [Google Scholar] [CrossRef]
- Silva, N.C.; Chevigny, C.; Domenek, S.; Almeida, G.; Assis, O.B.G.; Martelli-Tosi, M. Nanoencapsulation of active compounds in chitosan by ionic gelation: Physicochemical, active properties and application in packaging. Food Chem. 2025, 463, 141129. [Google Scholar] [CrossRef]
- Ishwarya, S.P.; Nisha, P. Advances and prospects in the food applications of pectin hydrogels. Crit. Rev. Food Sci. Nutr. 2022, 62, 4393–4417. [Google Scholar] [CrossRef]
- Kehinde, B.A.; Chhikara, N.; Sharma, P.; Garg, M.K.; Panghal, A. Application of polymer nanocomposites in food and bioprocessing industries. In Handbook of Polymer Nanocomposites for Industrial Applications; Elsevier: Amsterdam, The Netherlands, 2021; pp. 201–236. [Google Scholar]
- Feng, Z.; Sun, P.; Zhao, F.; Li, M.; Ju, J. Advancements and challenges in biomimetic materials for food preservation: A review. Food Chem. 2024, 463, 141119. [Google Scholar] [CrossRef]
- Lai, W.F. Design and application of self-healable polymeric films and coatings for smart food packaging. npj Sci. Food 2023, 7, 11. [Google Scholar] [CrossRef] [PubMed]
- Kothapalli, L.; Nikam, N.; Thomas, A.; Bhikne, N.; Kamdi, S. Pectin from Agro-waste to Utility Product. Curr. Green Chem. 2025, 12, 15–34. [Google Scholar] [CrossRef]
- Panda, J.; Mishra, A.K.; Mohanta, Y.K.; Patowary, K.; Rauta, P.R.; Mishra, B. Exploring biopolymer for food and pharmaceuticals application in the circular bioeconomy: An agro-food waste-to-wealth approach. Waste Biomass Valori. 2024, 15, 5607–5637. [Google Scholar] [CrossRef]
- Tuan, N.T.; Dang, L.N.; Huong, B.T.C.; Danh, L.T. One Step Extraction of Essential Oils and Pectin from Pomelo (Citrus grandis) Peels. Chem. Eng. Process. Process Intensif. 2019, 142, 107550. [Google Scholar] [CrossRef]
- Zellner, B.D.A.; Bicchi, C.; Dugo, P.; Rubiolo, P.; Dugo, G.; Mondello, L. Linear retention indices in gas chromatographic analysis: A review. Flavour Frag. J. 2008, 23, 297–314. [Google Scholar] [CrossRef]
- Zerrad, H.; Bakrim, H.; Moullamri, M.; Bakkali, M.; Alibrando, F.; Cacciola, F.; Mondello, M.; Dugo, P.; Mondello, L.; Arakrak, A.; et al. Chemical screening, antimicrobial and antioxidant activities of Ruta angustifolia essential oil from Morocco. J. Essent. Oil Res. 2024, 36, 173–184. [Google Scholar] [CrossRef]
- Akachat, B.; Himed, L.; Salah, M.; D’Elia, M.; Rastrelli, L.; Barkat, M. Development of Pectin-Based Films with Encapsulated Lemon Essential Oil for Active Food Packaging: Improved Antioxidant Activity and Biodegradation. Foods 2025, 14, 353. [Google Scholar] [CrossRef]
- Kerbab, K.; Sanah, I.; Djeghim, F.; Belattar, N.; Santoro, V.; D’Elia, M.; Rastrelli, L. Nutritional Composition, Physicochemical Properties, Antioxidant Activity, and Sensory Quality of Matricaria chamomilla-Enriched Wheat Bread. Foods 2025, 14, 838. [Google Scholar] [CrossRef]
- Laghezza Masci, V.; Mezzani, I.; Alicandri, E.; Tomassi, W.; Paolacci, A.R.; Covino, S.; Vinciguerra, V.; Catalani, E.; Cervia, D.; Ciaffi, M.; et al. The Role of Extracts of Edible Parts and Production Wastes of Globe Artichoke (Cynara cardunculus L. var. scolymus (L.) in Counteracting Oxidative Stress. Antioxidants 2025, 14, 116. [Google Scholar] [CrossRef]
- Szydłowska-Czerniak, A.; Dianoczki, C.; Recseg, K.; Karlovits, G.; Szłyk, E. Determination of Antioxidant Capacities of Vegetable Oils by Ferric-Ion Spectrophotometric Methods. Talanta 2008, 76, 899–905. [Google Scholar] [CrossRef] [PubMed]
- Özyürek, M.; Güngör, N.; Baki, S.; Güçlü, K.; Apak, R. Development of a silver nanoparticle-based method for the antioxidant capacity measurement of polyphenols. Anal. Chem. 2012, 84, 8052–8059. [Google Scholar] [CrossRef] [PubMed]
- Zhang, D.; Chen, D.; Campanella, O.H. The Effect of CaCl2 on the Gelling Properties of Pea Protein–Pectin Dispersions. Gels 2024, 11, 18. [Google Scholar] [CrossRef]
- Almeida, F.D.L.; Genisheva, Z.; Oliveira, J.M.; Vicente, A.A.; Teixeira, J.A. Pectin microparticles with lemon essential oil for antimicrobial applications. Food Bioprod. Process. 2018, 109, 29–39. [Google Scholar]
- Subhashree, S.N.; Sunoj, S.; Xue, J.; Bora, G.C. Quantification of browning in apples using colour and textural features by image analysis. Food Qual. Saf. 2017, 1, 221–226. [Google Scholar] [CrossRef]
- Modica, G.; Strano, T.; Napoli, E.; Seminara, S.; Aguilar-Hernández, M.; Legua, P.; Gentile, A.; Ruberto, G.; Continella, A. Qualitative traits and peel essential oil profiles of 24 Italian and international lemon varieties. Food Biosci. 2024, 59, 103881. [Google Scholar] [CrossRef]
- Güzel, B.; Canlı, O.; Yüce, B.; Hocaoglu, S.M. Determination of limonene chirality in oils obtained from different types of Citrus waste peels in Türkiye. J. Turk. Chem. Soc. A Chem. 2024, 11, 453–460. [Google Scholar] [CrossRef]
- Guo, Y.; Baschieri, A.; Amorati, R.; Valgimigli, L. Synergic antioxidant activity of γ-terpinene with phenols and polyphenols enabled by hydroperoxyl radicals. Food Chem. 2021, 345, 128468. [Google Scholar] [CrossRef]
- da Silva Martins, L.H.; da Silva, S.B.; Filho, A.F.; Komesu, A.; de Oliveira, J.A.R.; Moreira, D.K. T Essential Oils Used to Inhibit Bacterial Growth in Food. In Essential Oils: Extraction Methods and Applications; John Wiley and Sons: Hoboken, NJ, USA, 2023; pp. 31–47. [Google Scholar]
- Aelenei, P.; Miron, A.; Trifan, A.; Bujor, A.; Gille, E.; Aprotosoaie, A.C. Essential oils and their components as modulators of antibiotic activity against gram-negative bacteria. Medicines 2016, 3, 19. [Google Scholar] [CrossRef]
- Boukhatem, M.N.; Ferhat, M.A.; Kameli, A.; Saidi, F.; Mekarnia, M.A. Lemon Essential Oil: Antifungal Activity and Mode of Action against Fusarium oxysporum f. sp. albedinis. J. Essent. Oil Res. 2021, 33, 472–479. [Google Scholar]
- Viuda-Martos, M.; Ruiz-Navajas, Y.; Fernández-López, J.; Pérez-Álvarez, J. Antifungal activity of lemon (Citrus lemon L.), mandarin (Citrus reticulata L.), grapefruit (Citrus paradisi L.) and orange (Citrus sinensis L.) essential oils. Food Control 2008, 19, 1130–1138. [Google Scholar] [CrossRef]
- Singh, P.; Shukla, R.; Prakash, B.; Kumar, A.; Singh, S.; Dubey, N.K. Chemical profile, antifungal, antiaflatoxigenic andantioxidant activity of Citrus limon essential oil and its efficacy as a preservative against fungal spoilage of dry fruits. LWT-Food Sci. Technol. 2010, 43, 1117–1124. [Google Scholar]
- Gao, T.; Zhou, H.; Zhou, W.; Hu, L.; Chen, J.; Shi, Z. The fungicidal activity of thymol against Fusarium graminearum via inducing lipid peroxidation and disrupting ergosterol biosynthesis. Molecules 2016, 21, 770. [Google Scholar] [CrossRef]
- Rajčević, N.; Bukvički, D.; Dodoš, T.; Marin, P.D. Interactions between natural products-A review. Metabolites 2022, 12, 1256. [Google Scholar] [CrossRef] [PubMed]
- Ben Jemaa, J.M.; Tersim, N.; Khouja, M.L.; Ben Jilani, L.; Hamrouni, I. Insecticidal and Antioxidant Activities of Essential Oils from Citrus limon (L.) Osbeck Leaves. Ind. Crops Prod. 2012, 40, 77–82. [Google Scholar]
- Bibi Sadeer, N.; Montesano, D.; Albrizio, S.; Zengin, G.; Mahomoodally, M.F. The versatility of antioxidant assays in food science and safety, Chemistry, applications, strengths, and limitations. Antioxidants 2020, 9, 709. [Google Scholar] [CrossRef] [PubMed]
- Bachari, S.; Ghaderi-Ghahfarokhi, M.; Gavlighi, H.A.; Zarei, M. Ultrasonic depolymerization of pomegranate peel pectin: Effect of sonication time on antioxidant, α-amylase inhibitory, and prebiotic properties. Food Chem. X 2024, 24, 101901. [Google Scholar] [CrossRef]
- Larsen, L.R.; van der Weem, J.; Caspers-Weiffenbach, R.; Schieber, A.; Weber, F. Effects of ultrasound on the enzymatic degradation of pectin. Ultrason. Sonochem. 2021, 72, 105465. [Google Scholar] [CrossRef]
- Vela, A.J.; Villanueva, M.; Ronda, F. Ultrasonication: An efficient alternative for the physical modification of starches, flours and grains. Foods 2024, 13, 2325. [Google Scholar] [CrossRef]
- Kumar, A.R.S.; Padmakumar, A.; Kalita, U.; Samanta, S.; Baral, A.; Singha, N.K.; Ashokkumar, M.; Qiao, G.G. Ultrasonics in polymer science: Applications and challenges. Prog. Mater. Sci. 2023, 136, 101113. [Google Scholar] [CrossRef]
- Yang, X.; Lv, Z.; Han, C.; Zhang, J.; Duan, Y.; Guo, Q. Stability and encapsulation properties of daidzein in zein/carrageenan/sodium alginate nanoparticles with ultrasound treatment. Int. J. Biol. Macromol. 2024, 262, 130070. [Google Scholar] [CrossRef] [PubMed]
- Dhanasekaran, S.; Liang, L.; Gurusamy, S.; Yang, Q.; Zhang, H. Chitosan stabilized lemon essential oil nanoemulsion controls black mold rot and maintains quality of table grapes. Int. J. Biol. Macromol. 2024, 277, 134251. [Google Scholar] [CrossRef] [PubMed]
- Dhanasekaran, S.; Liang, L.; Gurusamy, S.; Godana, E.A.; Yang, Q.; Zhang, H. Efficacy and mechanism of chitosan nanoparticles containing lemon essential oil against blue mold decay of apples. Int. J. Biol. Macromol. 2025, 308, 142633. [Google Scholar] [CrossRef]
- Li, Y.; Sun, J.; Ai, C.; Song, S.; Yang, J. Edible Nano-Film Incorporated with Lemon Essential Oil-Loaded Pickering Emulsion for Cold Storage Improvement of Penaeus vannamei. Food Biosci. 2025, 69, 106900. [Google Scholar] [CrossRef]
- Sharma, R.; Nath, P.C.; Das, P.; Rustagi, S.; Sharma, M.; Sridhar, N.; Hazarika, T.K.; Rana, P.; Nayak, P.K.; Sridhar, K. Essential oil-nanoemulsion based edible coating: Innovative sustainable preservation method for fresh/fresh-cut fruits and vegetables. Food Chem. 2024, 460, 140545. [Google Scholar] [CrossRef] [PubMed]
- Taban, A.; Haghighi, T.M.; Mousavi, S.S.; Sadeghi, H. Are edible coatings (with or without essential oil/extract) game changers for maintaining the postharvest quality of strawberries? A meta-analysis. Postharvest Biol. Technol. 2024, 216, 113082. [Google Scholar] [CrossRef]
- Zdulski, J.A.; Rutkowski, K.P.; Konopacka, D. Strategies to Extend the Shelf Life of Fresh and Minimally Processed Fruit and Vegetables with Edible Coatings and Modified Atmosphere Packaging. Appl. Sci. 2024, 14, 11074. [Google Scholar] [CrossRef]
- Akbari, S.; Radi, M.; Hosseinifarahi, M.; Amiri, S. Microbial and physicochemical changes in green bell peppers treated with ultrasonic-assisted washing in combination with Thymus vulgaris essential oil nanocapsules. Sci. Rep. 2024, 14, 16584. [Google Scholar] [CrossRef] [PubMed]

| No. | RT (Min) | Compound Name | LRI | Area (%) ± SD |
|---|---|---|---|---|
| 1 | 7.984 | 1-Phellandrene | 714 | 0.67 ± 0.02 |
| 2 | 8.302 | α-Pinene | 930 | 2.82 ± 0.08 |
| 3 | 9.156 | Camphene | 968 | 0.12 ± 0.00 |
| 4 | 11.198 | β-Pinene | 982 | 9.89 ± 0.30 |
| 5 | 12.122 | Bicycloheptane dimethyl methylene | 1015 | 0.03 ± 0.00 |
| 6 | 12.640 | β-Myrcene | 1020 | 2.54 ± 0.08 |
| 7 | 15.978 | L-Limonene | 1030 | 56.18 ± 1.69 |
| 8 | 17.002 | D-Limonene | 1032 | 1.56 ± 0.05 |
| 9 | 17.596 | γ-Terpinene | 1064 | 9.75 ± 0.29 |
| 10 | 19.450 | α-Terpinolene | 1085 | 0.58 ± 0.02 |
| 11 | 21.234 | Cyclohexene methyl | 1132 | 0.02 ± 0.00 |
| 12 | 22.723 | cis-Limonene oxide | 1131 | 0.43 ± 0.01 |
| 13 | 23.106 | Spiroheptane derivative | 1180 | 0.47 ± 0.01 |
| 14 | 23.653 | 4,8-Epoxy-p-menth-1-ene | 1200 | 0.14 ± 0.00 |
| 15 | 24.542 | Citronellal | 1235 | 0.17 ± 0.01 |
| 16 | 26.449 | 3-Cyclohexen-1-ol derivative | 1250 | 0.02 ± 0.00 |
| 17 | 28.374 | Cyclohexene methanol | 1300 | 0.12 ± 0.00 |
| 18 | 30.775 | Z-Citral | 1320 | 1.60 ± 0.05 |
| 19 | 32.971 | Z-Citral/Cis-Citral | 1350 | 2.19 ± 0.07 |
| 20 | 38.333 | Tetramethylcyclopentenone | 1390 | 0.62 ± 0.02 |
| 21 | 39.069 | cis-Neryl acetate | 1410 | 1.94 ± 0.06 |
| 22 | 40.346 | Neryl/Geranyl acetate | 1430 | 1.49 ± 0.04 |
| 23 | 41.659 | Isocaryophyllene | 1450 | 0.93 ± 0.03 |
| 24 | 42.989 | trans-α-Bergamotene | 1470 | 1.77 ± 0.05 |
| 25 | 44.631 | trans-β-Farnesene | 1400 | 0.20 ± 0.01 |
| 26 | 45.962 | Cyclohexene derivative | 1510 | 0.06 ± 0.00 |
| 27 | 46.356 | Valencene | 1530 | 0.14 ± 0.00 |
| 28 | 47.351 | cis-α-Bisabolene | 1540 | 0.12 ± 0.00 |
| 29 | 47.680 | β-Bisabolene | 1570 | 3.01 ± 0.09 |
| 30 | 49.670 | trans-α-Bisabolene | 1590 | 0.06 ± 0.00 |
| 31 | 51.518 | Octahydro-inden-4-ol | 1600 | 0.33 ± 0.01 |
| Microorganism | Inhibition Zone (mm) | Sensitivity Level |
|---|---|---|
| Escherichia coli | 16.5 ± 0.41 | ++ |
| Salmonella spp. | 9.0 ± 0.86 | + |
| Bacillus cereus | 29.1 ± 1.15 | +++ |
| Staphylococcus aureus | 26.6 ± 1.60 | +++ |
| EO Concentration | F. oxysporum | A. niger | Botrytis spp. | Penicillium spp. |
|---|---|---|---|---|
| 0.3% | 15.38% ± 0.9% | 58.18% ± 2.4% | 59.3% ± 1.9% | 40.0% ± 2.0% |
| 0.15% | 10.66% ± 0.7% | 34.54% ± 1.4% | 44.18% ± 1.5% | 31.42% ± 1.2% |
| 0.075% | 5.33% ± 0.4% | 31.54% ± 1.3% | 39.53% ± 1.2% | 20.0% ± 0.8% |
| Sample | DPPH IC50 | ABTS IC50 | Phenanthroline A0 5 | FRAP A0 5 | SNP A0 5 |
|---|---|---|---|---|---|
| Lemon EO | 28.43 ± 0.14 | 35.01 ± 0.11 | 187.84 ± 0.34 | 66.59 ± 0.45 | 29.67 ± 0.05 |
| BHA | 5.99 ± 0.64 | 1.83 ± 0.67 | 0.94 ± 0.05 | ND | ND |
| BHT | 12.99 ± 0.41 | 1.53 ± 0.40 | 2.29 ± 0.10 | ND | ND |
| α-Tocopherol | ND | ND | ND | 35.26 ± 0.39 | ND |
| Trolox | ND | ND | ND | ND | 34.17 ± 1.23 |
| Parameter | C1 (Control) | C2 (Pectin Only) | C3 (Pectin + EO) |
|---|---|---|---|
| Browning Score (Day 6) | 2.8 ± 0.2 a | 2.3 ± 0.2 b | 1.2 ± 0.3 c |
| L* (Lightness, Day 10) | 59.4 ± 1.8 a | 63.8 ± 1.6 b | 69.3 ± 1.1 c |
| a* (Redness, Day 10) | 5.6 ± 0.4 a | 4.4 ± 0.3 b | 3.2 ± 0.3 c |
| b* (Yellowness, Day 10) | 22.6 ± 0.6 a | 23.0 ± 0.5 a | 23.4 ± 0.4 a |
| Aerobic Bacteria (log CFU/g, Day 10) | 6.5 ± 0.4 a | 5.8 ± 0.3 b | 4.9 ± 0.2 c |
| Fungal Count (log CFU/g, Day 10) | 4.4 ± 0.3 a | 3.6 ± 0.2 b | 3.1 ± 0.3 c |
| Weight Loss (%, Day 10) | 6.4 ± 0.5 a | 5.1 ± 0.4 b | 4.2 ± 0.3 c |
| Firmness (N, Day 10) | 1.4 ± 0.2 a | 1.9 ± 0.2 b | 2.3 ± 0.1 c |
Disclaimer/Publisher’s Note: The statements, opinions and data contained in all publications are solely those of the individual author(s) and contributor(s) and not of MDPI and/or the editor(s). MDPI and/or the editor(s) disclaim responsibility for any injury to people or property resulting from any ideas, methods, instructions or products referred to in the content. |
© 2025 by the authors. Licensee MDPI, Basel, Switzerland. This article is an open access article distributed under the terms and conditions of the Creative Commons Attribution (CC BY) license (https://creativecommons.org/licenses/by/4.0/).
Share and Cite
Djerri, R.; Merniz, S.; D’Elia, M.; Aissani, N.; Khemili, A.; Abou Mustapha, M.; Rastrelli, L.; Himed, L. Ultrasound-Enhanced Ionotropic Gelation of Pectin for Lemon Essential Oil Encapsulation: Morphological Characterization and Application in Fresh-Cut Apple Preservation. Foods 2025, 14, 1968. https://doi.org/10.3390/foods14111968
Djerri R, Merniz S, D’Elia M, Aissani N, Khemili A, Abou Mustapha M, Rastrelli L, Himed L. Ultrasound-Enhanced Ionotropic Gelation of Pectin for Lemon Essential Oil Encapsulation: Morphological Characterization and Application in Fresh-Cut Apple Preservation. Foods. 2025; 14(11):1968. https://doi.org/10.3390/foods14111968
Chicago/Turabian StyleDjerri, Rofia, Salah Merniz, Maria D’Elia, Nadjwa Aissani, Aicha Khemili, Mohamed Abou Mustapha, Luca Rastrelli, and Louiza Himed. 2025. "Ultrasound-Enhanced Ionotropic Gelation of Pectin for Lemon Essential Oil Encapsulation: Morphological Characterization and Application in Fresh-Cut Apple Preservation" Foods 14, no. 11: 1968. https://doi.org/10.3390/foods14111968
APA StyleDjerri, R., Merniz, S., D’Elia, M., Aissani, N., Khemili, A., Abou Mustapha, M., Rastrelli, L., & Himed, L. (2025). Ultrasound-Enhanced Ionotropic Gelation of Pectin for Lemon Essential Oil Encapsulation: Morphological Characterization and Application in Fresh-Cut Apple Preservation. Foods, 14(11), 1968. https://doi.org/10.3390/foods14111968

